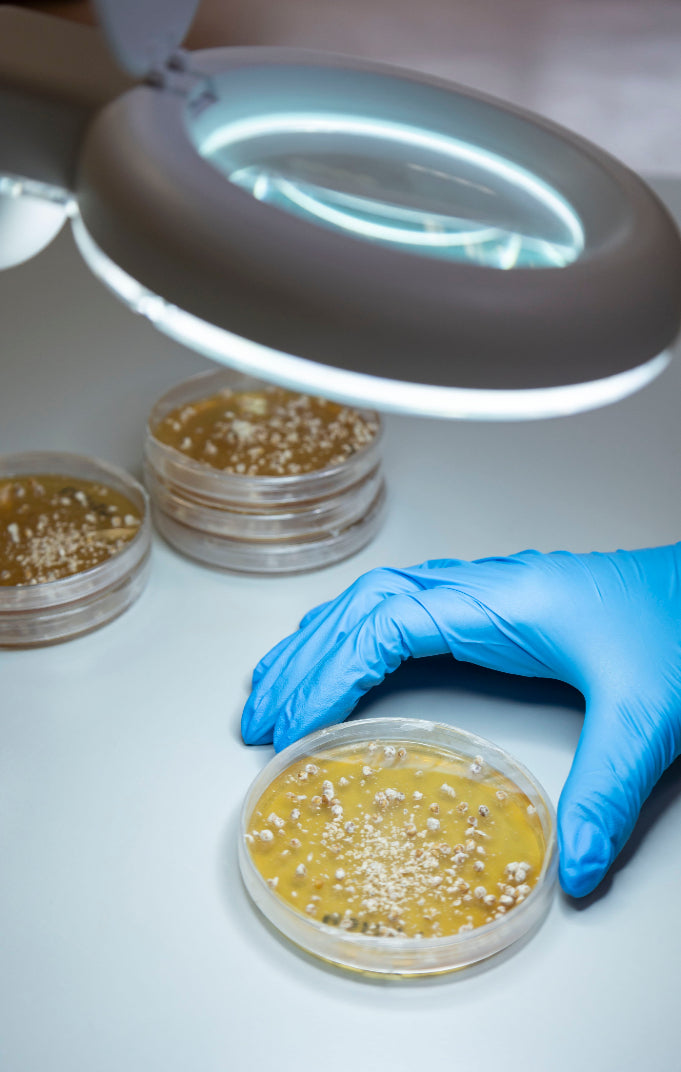

Materials Engineered for Excellence.
Introducing the world’s most advanced mycelium textile. Farm-grown from the root structure
of mushrooms. Forager delivers luxurious raw cow hide-like textures and plush foams—without the animal.

Our Products

AirLoom® Hides
High-performance botanical hides with unique, and naturally grown textures and customizable colors, finishes and thickness for versatile applications.

MycoFlex® Foam
100% biobased, pure mycelium foam that’s antimicrobial, thermally insulating, flame resistant, and aerobically compostable, grown in just 7 to 9 days.
Technology Meets Craftmanship

Authentic Texture
Naturally grown mycelium structure—no grinding or binding, ensuring a unique and genuine feel.
Proven Innovation
Backed by 165+ patents and 15 years of pioneering breakthroughs in molecular mycotechnology.

Scalable
Scalable in global farm infrastructure with 450mill. sqm/year available global capacity.

100% Biobased
Renewable Raw Material – customizable with a wide range of finishing options to suit your needs.

Reduced Carbon Footprint
Significantly lower CO₂ emissions compared to traditional raw cow hide; designed for a circular lifecycle.

Versatile Applications
Ideal for handbags, footwear, accessories, apparel, and more
